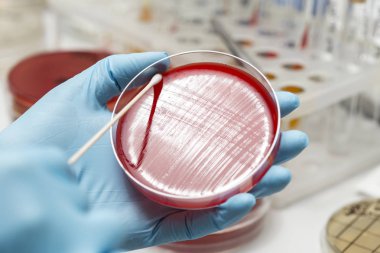
Laboratuvar teknisyeninin eli petri kabı yerleştiriyor.

Laboratuvar teknisyeninin eli petri kabı yerleştiriyor.
İhlal Bildirim Formu
Özel Boyut
(5489 x 3659, jpg)
Geniş Lisanslama
(5489 x 3659, jpg)
* Kurumsal aylık abonelikte çok avantajlı fiyatlar için tıklayın.
* Fiyatlara Kdv dahil değildir.
Örnek Kullanımlar: Web siteleri; reklam afişleri; ekran koruyucuları; sunumlar (PowerPoint, Flash, vs); filmler, videolar veya televizyon reklamları, gazete ve dergilerdeki reklamlar, bastırılmış reklam materyalleri; kitaplar için kapak, iş kartları; el ilanları; posterler; CD/DVD kapakları, etiketler veya ürün paketleri, kırtasiye, dosya, defterler, tükenmez kalem, kalemler, yapıştırmalar; takvimler; fincanlar veya bardaklar; fare altlığı; tişörtler, kıyafet vs. Detaylı Tablo için Tıklayınız!
En Çok Aranan Kelimeler
İzole edilmişdonanımTutuluyorbüyümeSağlıkTabakİlaç.Sağlık hizmetleriTıbbiteknolojiEl.biyolojikHücreTest etkoruyucuHastalıkkültürörnekbiyolojiDeneyLaboratuvarBilimanalizortamvirüsBakteriaraştırmaeldivenBilimselorganizmaTeknisyenmantarlarBiyoteknoloji.bilim adamıBakterilerMikroskopDöngüMikrobiyolojiKolonimikroplarEnfeksiyonaşılamaPetripastörimmanuel kantBenzer İçerikler